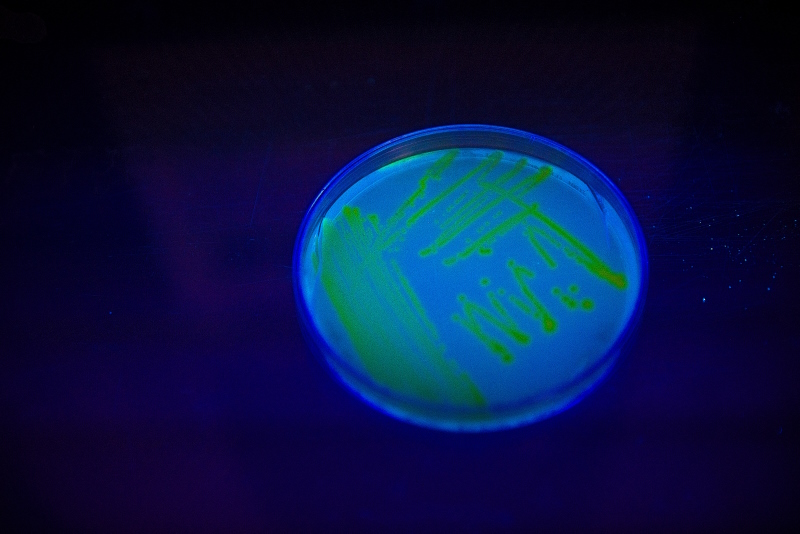

As part of our ongoing scope review, Open Biology is pleased to share some updates that strengthen the journal’s identity and clarify our remit within the life sciences.

A renewed focus on mechanistic biology
The Board has agreed that Open Biology will place stronger emphasis on mechanistic studies in cell and molecular biology, positioning the journal as a home for research that provides deeper insight into the underlying processes of life.
Many of our most-read and most-cited papers already reflect this direction. Recent examples include:
- studies uncovering the mechanistic drivers behind cell structure organisation
- open question revealing mechanistic steps in gene regulation and transcriptional control
- resource looking at pathogen-host molecular interactions and antiviral studies
- work exploring the molecular basis of cell-cycle progression
- mechanistic review of host-parasite interactions
These papers exemplify the kind of detailed mechanistic insight we aim to champion and expand upon. We now also welcome methods and resource papers that enable advances in mechanistic biology and provide lasting value to the community, whether through new experimental techniques, analytical tools, or datasets that support discovery.
How we sit alongside our sister journals
To help authors, editors, and reviewers navigate the Royal Society’s journal portfolio:
- Open Biology focuses on cellular, molecular, and mechanistic biology, including methodological innovations
- Proceedings B covers all of the biological sciences in whole organisms, with ecology, evolution, and behaviour the core subject areas
- Biology Letters specialises in short articles across the biological sciences
- Philosophical Transactions B publishes theme issues and commissioned collections across the life sciences
- Royal Society Open Science remains broad, covering all sciences with a strong commitment to open science practices
Submit your work
We invite authors to submit original research, reviews, and methods/resource papers that deepen mechanistic understanding in biology. You can learn more about our updated scope and submission criteria on our Aims and scope page.